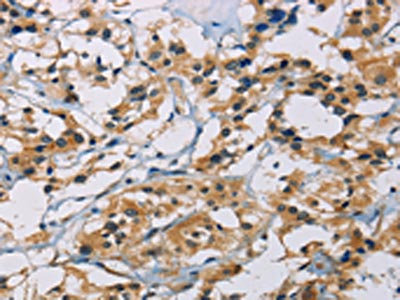

CSNK1E Antibody
-
中文名稱:CSNK1E兔多克隆抗體
-
貨號:CSB-PA156748
-
規(guī)格:¥1100
-
圖片:
-
其他:
產(chǎn)品詳情
-
Uniprot No.:
-
基因名:CSNK1E
-
別名:Casein kinase 1 epsilon antibody; Casein kinase I antibody; Casein kinase I epsilon antibody; Casein kinase I isoform epsilon antibody; CKI epsilon antibody; CKI-epsilon antibody; CKIe antibody; CKIepsilon antibody; CSNK 1E antibody; CSNK1E antibody; DBT antibody; Doubletime, Drosophila, homolog of antibody; EC 2.7.11.1 antibody; epsilon isoform antibody; HCK IE antibody; KC1E antibody; KC1E_HUMAN antibody; kinase CK1 epsilon antibody; MGC 10398 antibody
-
宿主:Rabbit
-
反應(yīng)種屬:Human,Mouse
-
免疫原:Fusion protein of Human CSNK1E
-
免疫原種屬:Homo sapiens (Human)
-
標記方式:Non-conjugated
-
抗體亞型:IgG
-
純化方式:Antigen affinity purification
-
濃度:It differs from different batches. Please contact us to confirm it.
-
保存緩沖液:-20°C, pH7.4 PBS, 0.05% NaN3, 40% Glycerol
-
產(chǎn)品提供形式:Liquid
-
應(yīng)用范圍:ELISA,IHC
-
推薦稀釋比:
Application Recommended Dilution ELISA 1:2000-1:5000 IHC 1:25-1:100 -
Protocols:
-
儲存條件:Upon receipt, store at -20°C or -80°C. Avoid repeated freeze.
-
貨期:Basically, we can dispatch the products out in 1-3 working days after receiving your orders. Delivery time maybe differs from different purchasing way or location, please kindly consult your local distributors for specific delivery time.
-
用途:For Research Use Only. Not for use in diagnostic or therapeutic procedures.
相關(guān)產(chǎn)品
靶點詳情
-
功能:Casein kinases are operationally defined by their preferential utilization of acidic proteins such as caseins as substrates. Can phosphorylate a large number of proteins. Participates in Wnt signaling. Phosphorylates DVL1 and DVL2. Central component of the circadian clock. In balance with PP1, determines the circadian period length, through the regulation of the speed and rhythmicity of PER1 and PER2 phosphorylation. Controls PER1 and PER2 nuclear transport and degradation. Inhibits cytokine-induced granuloytic differentiation.
-
基因功能參考文獻:
- CKI-epsilon is a potent TDP-43 kinase in vivo and in vitro. PMID: 24105464
-
亞細胞定位:Cytoplasm. Nucleus.
-
蛋白家族:Protein kinase superfamily, CK1 Ser/Thr protein kinase family, Casein kinase I subfamily
-
組織特異性:Expressed in all tissues examined, including brain, heart, lung, liver, pancreas, kidney, placenta and skeletal muscle. Expressed in monocytes and lymphocytes but not in granulocytes.
-
數(shù)據(jù)庫鏈接:
Most popular with customers
-
-
YWHAB Recombinant Monoclonal Antibody
Applications: ELISA, WB, IHC, IF, FC
Species Reactivity: Human, Mouse, Rat
-
Phospho-YAP1 (S127) Recombinant Monoclonal Antibody
Applications: ELISA, WB, IHC
Species Reactivity: Human
-
-
-
-
-